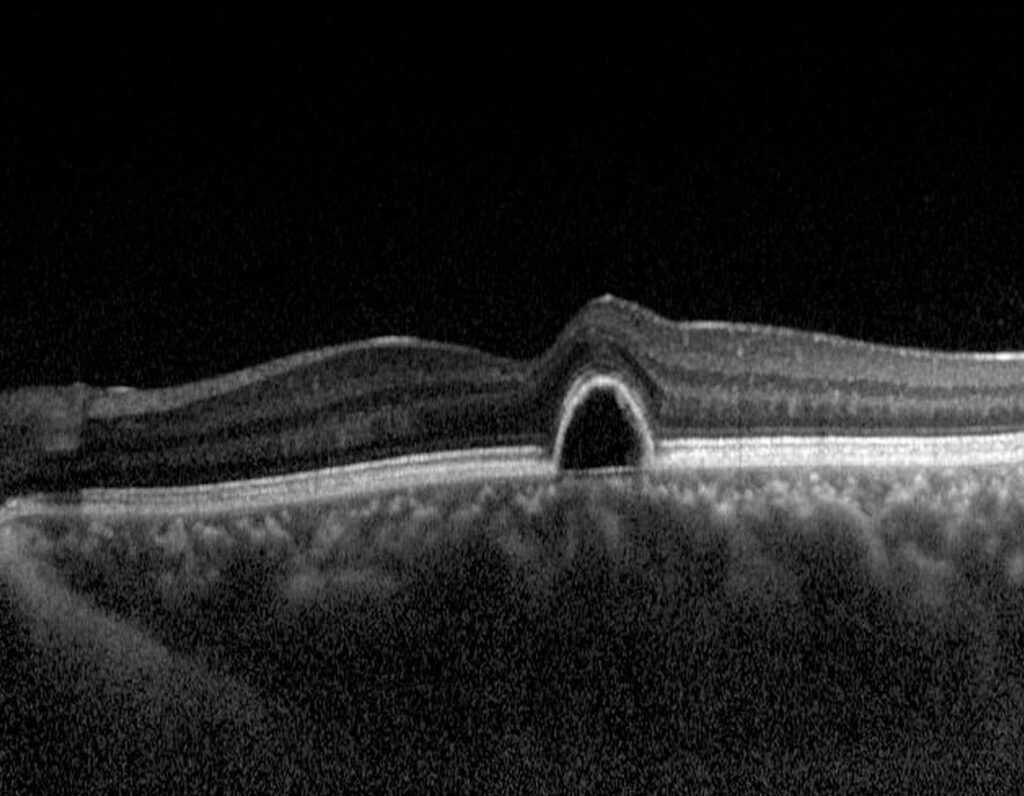

OCT
At Hill Vision, we use the latest in advanced technology to ensure the best care for your eyes. Among the state-of-the-art tools at our disposal is optical coherence tomography (OCT), a non-invasive scan, which takes detailed images of the layers inside your eye. An OCT helps us detect eye conditions early – often before you experience any symptoms – allowing us to stop emerging problems in their tracks and protect your long-term vision.
What is OCT?
OCT works by using light waves to capture cross-sectional images of your retina, which is the light-sensitive layer at the back of your eye. Think of it like an ultrasound for your eye but using light instead of sound. This allows us to see detailed pictures of your eye’s internal structures, not possible with a standard eye exam.
Why is OCT important?
OCT plays a crucial role in the early detection of many serious eye conditions. It allows us to monitor changes in the layers of your retina and other parts of your eye, which can indicate a developing eye issue. Catching problems early is vital in preventing potential or further damage to your vision.
What can OCT detect and diagnose?
OCT is particularly helpful for identifying and monitoring several eye conditions, including:
Age-related macular degeneration (ARMD): This condition affects the macula, the part of your retina responsible for central vision. OCT can detect early changes in the macula that may lead to ARMD, helping us intervene early to prevent further damage.
Glaucoma: This is a group of eye conditions that damage the optic nerve, which is crucial for vision. OCT allows us to monitor the optic nerve for signs of deterioration, often before other tests can detect it.
Diabetic retinopathy: High blood sugar from diabetes can damage the blood vessels in the retina. OCT can show changes in the retina indicating diabetic retinopathy, helping us to prevent long-term vision loss.
Vitreous detachment: The vitreous is the jelly-like substance inside your eye. As we age, it can start to pull away from the retina, causing symptoms like floaters. OCT can check for this, allowing us to manage any complications.
Macular holes: These are small breaks in the macula, the central part of the retina responsible for sharp, detailed vision. These holes can cause blurry central vision, making activities like reading or recognising faces difficult. OCT helps detect them early, allowing for timely treatment and prevention of further sight loss.
How OCT differs from Optomap
Optomap is another advanced imaging tool used to examine the retina. However, unlike OCT, it provides a wide-field image of the retina’s surface, allowing us to see the larger picture. OCT is designed to capture the individual layers of the retina. Together, they provide a thorough assessment of your eye health.